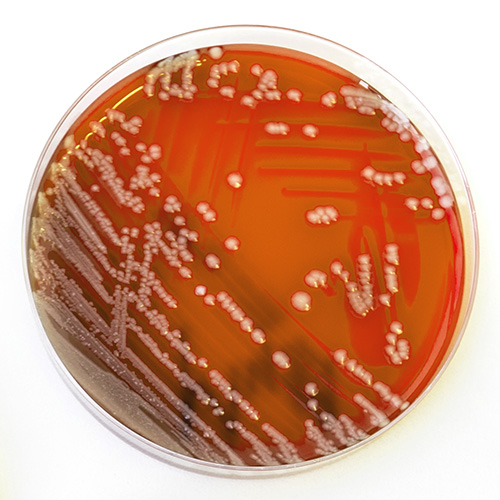
Bacteria colonies in Petri Dishes

When considering a filter for use with waterborne pathogens, it can be difficult to understand the differences in technologies so that the appropriate filter can be chosen. From one manufacturer or technology to the next, performance can vary significantly. To understand more about the different point-of-use water technologies, visit our blog: What is the technology inside a Point-of-Use water filter?
The American Society for Testing and Materials International (ASTM) has published a standard to judge the performance of a filter at 0.2 microns: the ASTM F838 (latest version ASTM F838-20) (1). However, to assess the results, it is first important to know a bit about how the test works.
What does the ASTM F838 - 20 test show?
The American Society for Testing and Materials International (ASTM) has published a standard to judge the performance of a filter to retain bacteria: the ASTM F838 (latest version ASTM F838-20) (https://www.astm.org/Standards/F838.htm). However, to assess the results, it is first important to know a bit about how the test works.
The number of organisms not retained by the filter are then enumerated and the level of bacterial removal (log/titer reduction) of bacteria by the filter can be quantified. This filter is known as a microbial filter, which leads to just a reduction of bacterial concentration downstream of the filter, or biodurden reduction. In the case that there are zero bacteria enumerated downstream of the filter, meaning that all bacteria have been retained by the specific filtration membrane area (absolute retention), this is known as a sterilizing-grade filter (2).
Interpreting results: Sterilizing grade vs. log reduction of bacteria
It is important to recognize that the ASTM F838-20 test is mostly relevant to 0.2 micron filters. If a filter claims to have a smaller pore size, for example 0.1 micron, then the filter should be validated with a different organism, often mycoplasma such as Acholeplasma laidlawii in this example (3). It is also not correct to assume that a 0.1 micron filter will retain all 0.2 micron particles or microorganisms. Results depend heavily on the type and quality of the filter technology.
Therefore, when choosing a Point-of-Use water filter, a copy of the results from the ASTM F838-20 test should be included in the product documentation and reviewed by the user. Some questions to ask and verify are: Is this filter sterilizing-grade? If not, what is the log reduction of the challenge organism? Has the filter been challenged with the correct concentration of Brevundimonas diminuta? What is the membrane surface used within the filter?
The choice between a sterilizing-grade for absolute retention and microbial filter for bioburden reduction may arise. Some may think that a microbial filter and sterilizing-grade filter are not so different. However, even a small number of bacteria can cause an infection. For example, if a filter with a 7 log (99.99999%) reduction claim were to be challenged with >1010 (10,000,000,000) bacteria over its installation life, the expectation would be that >1,000 bacteria would be discharged to the environment or user. In many healthcare applications, this may still leave too much risk, so consider how and where this filter will be used. In areas and countries where legislation requires zero pathogens downstream of the filter in 100 ml or 1000 ml of water sample, sterilizing-grade filtration should be considered to enable compliance with the respective guidelines.
References
- American Society for Testing and Materials. ASTM F838-20, Standard Test Method for Determining Bacterial Retention of Membrane Filters Utilized for Liquid Filtration. 2020. www.astm.org. [Updated 2020 Oct 28]. doi:10.1520/F0838-20.
- United State Food and Drug Administration (US FDA). Guidance for Industry: Sterile Drug Products Produced by Aseptic Processing – Current Good Manufacturing Practice. FDA Docket Number: FDA-2003-D-0145. 2004 Oct. [Updated 2020 May 04].
- Folmsbee M, Roche Lentine K, Wright C, Haake G, Mcburnie L, Ashtekar D, et. al. The Development of a Microbial Challenge Test with Acholeplasma laidlawii To Rate Mycoplasma-Retentive Filters by Filter Manufacturers. PDA J Pharm Sci Technol. 2014;68(3):281-296. doi:10.5731/pdajpst.2014.00976.
Author bio
Marissa Khoukaz - Business Development Manager — Hospital Water

Marissa is a Business Development Manager for Hospital Water and manages the prefiltration portfolio globally for Cytiva. She works with high-risk units to reduce waterborne pathogen risk to patients.